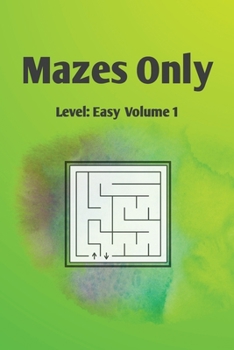
Paperback Mazes Only: Level: Easy Volume 1 Book

Mazes Only: Level: Easy Volume 1
This clean and simple puzzle book contains 48 mazes (with solutions in back). There's nothing on the page to distract from the mazes themselves.
Perfect gift for distractible kids, seniors, or those who need writing or fine motor skill practice.
Easy mazes are recommended by therapists to boost confidence. They provide a fun way for adults and kids to improve their fine motor skills and how to plan and execute controlled movements (especially post stroke or other neurological conditions).
Mazes are fun and a great boredom-buster. They help to:
Improve concentrationHone attention to detailStimulate logic Foster problem solving Build hand eye coordination and muscle memoryEntertain (without screens )These are truly beginner mazes. They may be too simple for some children and most adults. However, they're perfect for anyone focusing more on fine motor skills than the logic and puzzle solving aspects of mazes. If you're looking for more challenging mazes, please check out our other activity books.
This book is 6 x 9 inches or "pocket sized." This size is perfect to not overwhelm small or shaky hands. It makes a great stocking stuffer, and fits easily in a backpack or bag for travel.